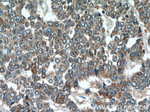
SIRT1 Antibody in Immunohistochemistry (Paraffin) (IHC (P))

Search
Proteintech
SIRT1 Polyclonal Antibody
{{$productOrderCtrl.translations['antibody.pdp.commerceCard.promotion.promotions']}}
{{$productOrderCtrl.translations['antibody.pdp.commerceCard.promotion.viewpromo']}}
{{$productOrderCtrl.translations['antibody.pdp.commerceCard.promotion.promocode']}}: {{promo.promoCode}} {{promo.promoTitle}} {{promo.promoDescription}}. {{$productOrderCtrl.translations['antibody.pdp.commerceCard.promotion.learnmore']}}
产品信息
13161-1-AP
种属反应
已发表种属
宿主/亚型
分类
类型
抗原
偶联物
形式
浓度
规格
纯化类型
保存液
内含物
保存条件
运输条件
产品详细信息
This antibody is a rabbit polyclonal antibody raised against residues near the N terminus of human SIRT1.
Immunogen sequence: MIGTDPRTI LKDLLPETIP PPELDDMTLW QIVINILSEP PKRKKRKDIN TIEDAVKLLQ ECKKIIVLTG AGVSVSCGIP DFRSRDGIYA RLAVDFPDLP DPQAMFDIEY FRKDPRPFFK FAKEIYPGQF QPSLCHKFIA LSDKEGKLLR NYTQNIDTLE QVAGIQRIIQ CHGSFATASC LICKYKVDCE AVRGALFSQV VPRCPRCPAD EPLAIMKPEI VFFGENLPEQ FHRAMKYDKD EVDLLIVIGS SLKVRPVALI PSSIPHEVPQ ILINREPLPH LHFDVELLGD CDVIINELCH RLGGEYAKLC CNPVKLSEIT EKPPRTQKEL AYLSELPPTP LHVSEDSSSP E (1-350 aa encoded by BC012499)
靶标信息
NAD-dependent protein deacetylase sirtuin-1 (SIRT1) links transcriptional regulation directly to intracellular energetics and participates in the coordination of several separated cellular functions such as cell cycle, repsonse to DNA damage, metabolism, apoptosis, and autophagy. SIRT1 can modulate chromatin function through deacetylation of histones and can promote alterations in the methylation of histone and DNA, leading to transcriptional repression. It is essential in skeletal muscle cell differentiation and in response to low nutrients mediates the inhibitory effect on skeletal myoblast differentiation which also involves 5'-AMP-activated protein kinase (AMPK) and nicotinamide phosphoribosyltransferase (NAMPT).
仅用于科研。不用于诊断过程。未经明确授权不得转售。
生物信息学
蛋白别名: domain has histone deacetylase activity; hSIR2; hSIRT1; NAD-dependent protein deacetylase sirtuin-1; NAD-dependent protein deacylase sirtuin-1; OTTHUMP00000198111; OTTHUMP00000198112; Regulatory protein SIR2 homolog 1; RP11-57G10.3; SIR2-like protein 1; SIRT 1; SIRT-1; sirtuin type 1; unnamed protein product; yeast silent information regulator 2 (Sir2p) homolog
基因别名: SIR2; SIR2alpha; SIR2L1; SIRT1
UniProt ID: (Human) Q96EB6
Entrez Gene ID: (Human) 23411